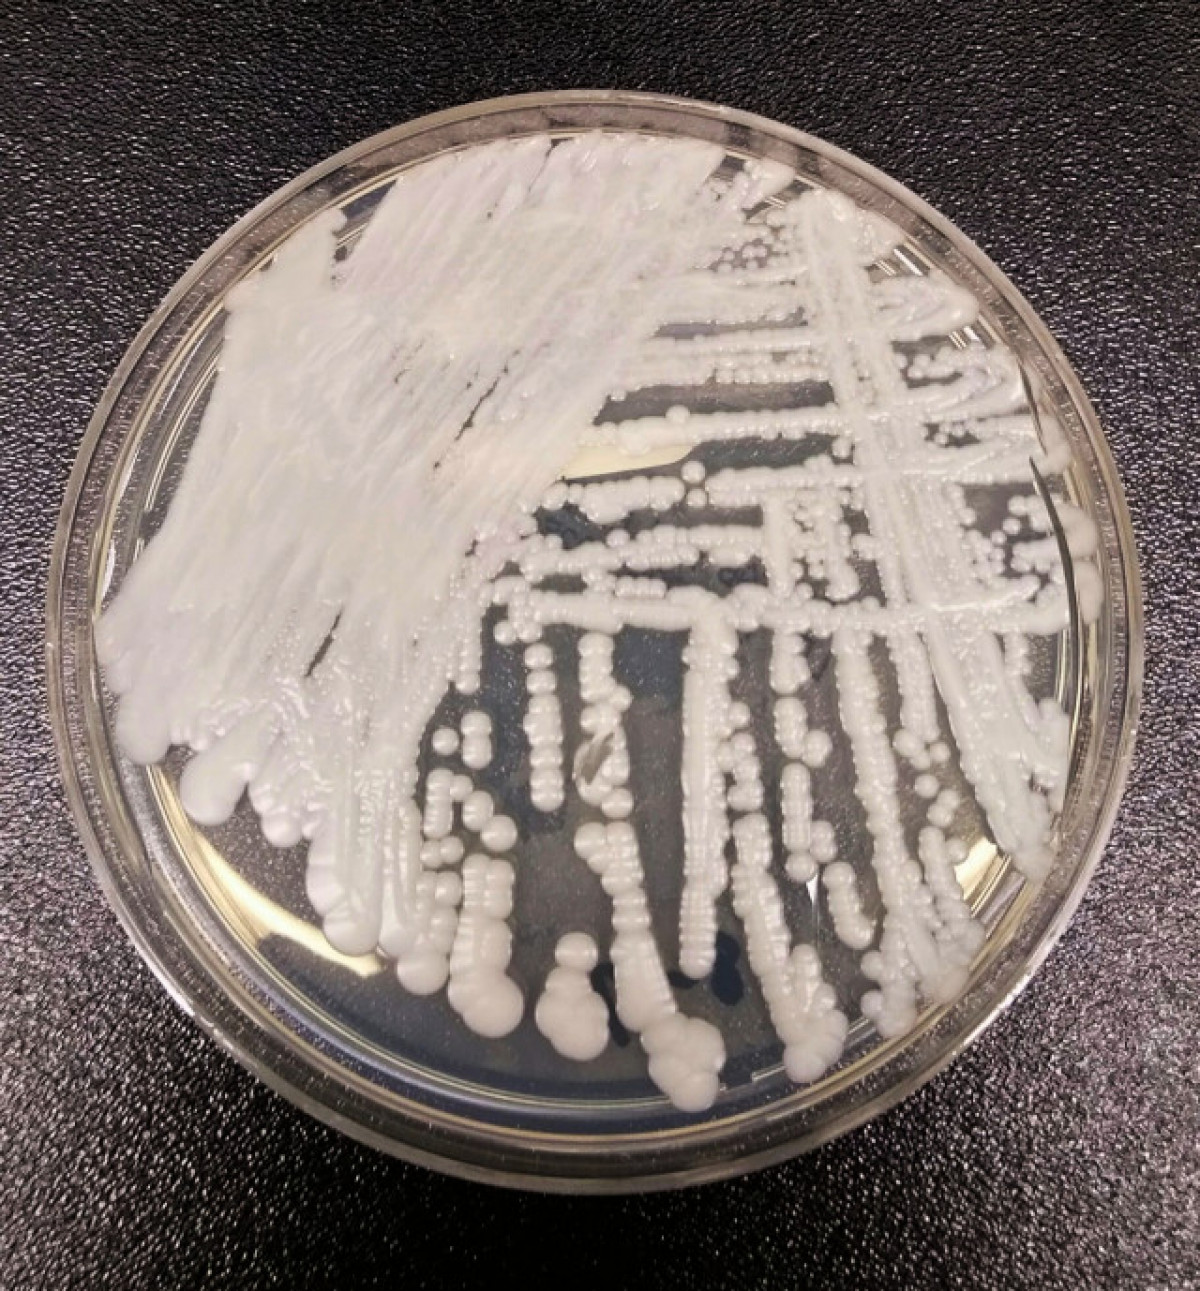

Un fong que mata 6 de cada 10 infectats s'està expandint ràpidament pels EUA
Els Centres per al Control i la Prevenció de Malalties (CDC) ja ho van descriure com una "amenaça urgent" el 2019, però les estadístiques mostren que les xifres han augmentat els últims quatre anys.

El Col·legi Nord-americà de Metges (ACAP) va emetre una advertència sobre l'augment d'un fong mortal, que va descriure com a "particularment preocupant". Els casos de Candida auris, més coneguda com a C auris, han augmentat ràpidament en els últims mesos, cosa que ha despertat el temor d'una altra pandèmia.
Els Centres per al Control i la Prevenció de Malalties (CDC) ja ho van descriure com una "amenaça urgent" el 2019, però les estadístiques mostren que les xifres han augmentat els últims quatre anys. Una nova investigació dels CDC ha revelat que el nombre de casos es va triplicar amb escreix als Estats Units entre el 2020 i el 2021. Es creu que el fong té una taxa de mortalitat del 60 per cent de les persones que infecta. És a dir, mata 6 de cada 10 infectats.
Una persona s'infecta després del contacte directe amb un objecte contaminat i es pot propagar entre humans a través del contacte directe. El rentat estricte de mans pot limitar la propagació.

Escriu el teu comentari